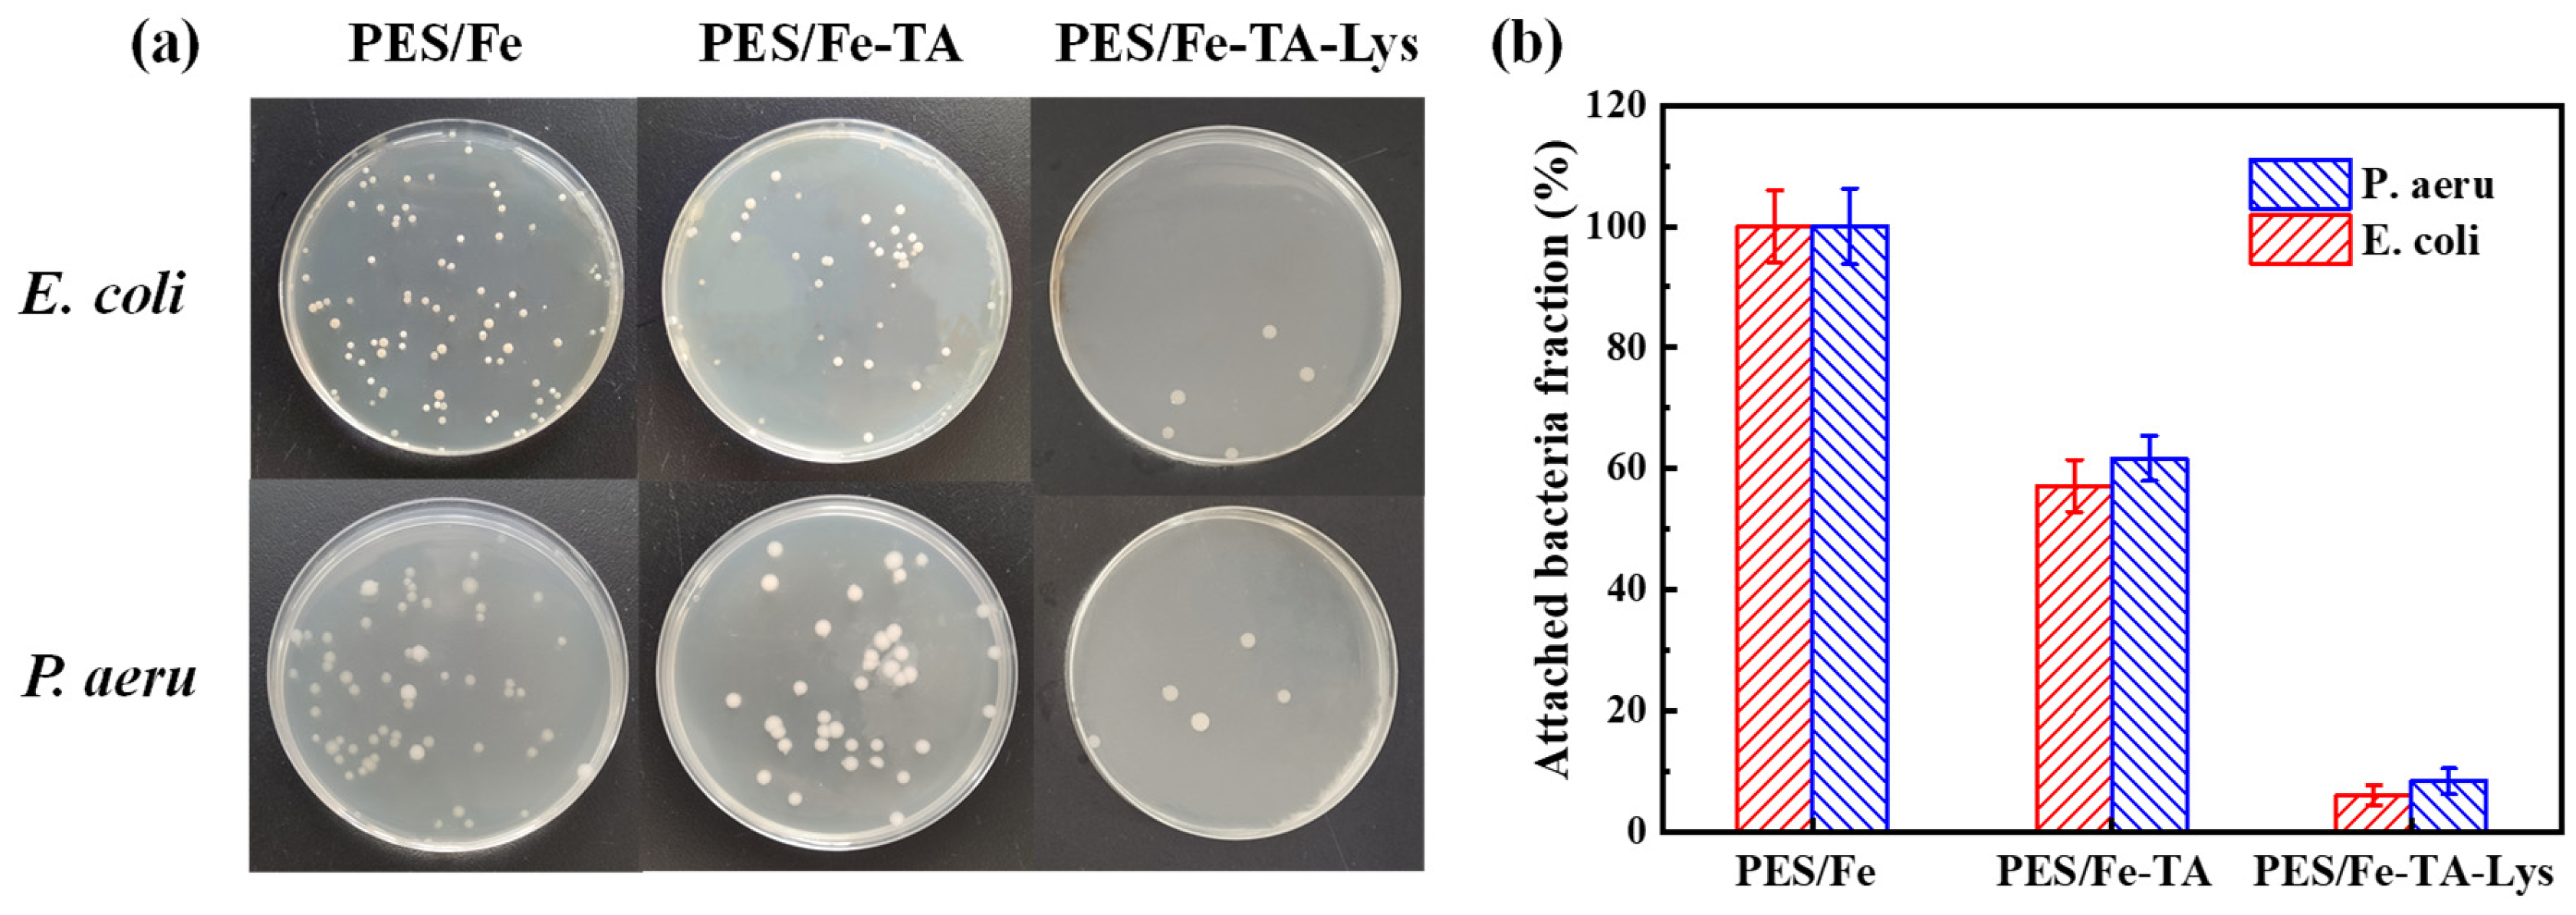
Separations 12 00129 g012

Abstract
Precise separation and antifouling capabilities are critical for the application of membrane separation technology. In this work, we developed a multiplayer layer-by-layer assembly strategy to sequentially deposit tannic acid (TA) and lysozyme (Lys) onto polyethersulfone/iron (PES/Fe) ultrafiltration membrane substrates, enabling the simple and efficient fabrication of a biofouling-resistant loose nanofiltration (LNF) membrane with superior dye/salt separation performance. This approach fully leverages the multifunctionality of TA by exploiting its coordination with Fe3⁺ and non-covalent interactions with Lys. The obtained PES/Fe-TA-Lys LNF membrane exhibits a pure water flux of 57.5 L·m−2·h−1, along with exceptional dye rejection rates (98.3% for Congo Red (CR), 99.2% for Methyl Blue (MB), 98.4% for Eriochrome Black T (EBT), and 67.6% for Acid Orange 74 (AO74)) while maintaining minimal salt retention (8.2% for Na2SO4, 4.3% for MgSO4, 3.5% for NaCl, and 2.4% for MgCl2). The PES/Fe-TA-Lys LNF membrane also displays outstanding antifouling performance against bovine serum albumin (BSA), humic acid (HA), and CR, along with strong biofouling resistance against Escherichia coli (E. coli) and Pseudomonas aeruginosa (P. aeruginosa) via synergistic anti-adhesion and biofilm inhibiting effects. This work presents a novel and scalable approach to fabricating biofouling-resistant LNF membranes, offering great potential for dye/salt separation in textile wastewater treatment.
1. Introduction
With rising population growth, accelerated industrialization, and a booming economy, a great deal of wastewater is produced and discharged into the environment [1,2]. In particular, textile wastewater has become one of the main contributors to water contamination owing to its toxicity, large water quality changes, high salinity, and chroma, leading to terrible water pollution, which is harmful to living beings, including humans [3]. The World Water Council estimates that the textile industry discharges approximately 1 billion tons of salty dye wastewater per year, which contributes significantly to concerns about potential water shortages [4]. The escalating global water crisis has necessitated the development of advanced textile wastewater treatment systems capable of simultaneous pollutant removal and resource reclamation. Numerous water treatment technologies, including advanced oxidation processes, biological degradation, adsorption, and electro-flocculation, have been developed and implemented for the treatment of textile dyeing wastewater [5]. However, these methods exhibit inherent limitations, including complex operational procedures, unavoidable loss of valuable components, and secondary pollution induced by chemical additives. Membrane-based separation processes, such as nanofiltration (NF), have gained attention as promising alternatives due to their high separation efficiency, low energy consumption, and versatility.
NF membranes have emerged as promising candidates for desalination and organic separation due to their excellent rejection of neutral molecules (150–2000 Da) and optimal pore size distribution [6,7,8]. However, conventional tight NF membranes with dense separation layers exhibit the high rejection of both organic solutes and salts [9,10,11], making precise dye/salt separation challenging. Compared to conventional tight NF membranes, loose nanofiltration (LNF) membranes are characterized by larger pore sizes (0.5–2 nm) and higher water permeability (>50 L·m−2·h−1·bar−1), enabling selective solute–solute separation [12]. These features enable precise solute–solute differentiation, particularly in textile wastewater remediation, where simultaneous dye recovery and salt permeation are essential [13,14]. The unique selectivity profile of LNF membranes demonstrates >90% rejection efficiency for dyes and organic macromolecules, while maintaining minimal salt retention (<10% for NaCl) [15]. Operationally, tight NF membranes typically require high pressures (>8 bar) to overcome their dense layer resistance [16], yielding modest fluxes (20–40 L·m−2·h−1), while LNF membranes achieve efficient fractionation at low pressures (<3 bar) with higher permeability (50–100 L·m−2·h−1). For instance, recent TA-based LNF membranes demonstrated stable CR rejection (>99.8%) and low NaCl rejection (<1.5%) at just 2 bar, highlighting their energy-saving advantages for textile wastewater treatment [17], underscoring their energy-efficient advantages for industrial wastewater valorization. To optimize their performance, researchers have explored various strategies, including surface modification (e.g., chemical grafting, layer-by-layer assembly) and the incorporation of nanomaterials (e.g., GO, MOFs) [18,19]. However, membrane fouling remains a critical challenge, significantly hindering their practical implementation. Fouling primarily arises from the deposition of dyes and salts on the membrane surface, which reduces separation efficiency, increases energy demands, and raises operational costs. Moreover, in wastewater treatment scenarios, microbial adhesion and subsequent biofilm formation can lead to severe biofouling, further compromising long-term performance. Therefore, developing membranes with enhanced fouling resistance is of paramount importance to improve the efficiency and sustainability of dye/salt separation processes.
To combat organic fouling, strategies such as hydrophilic coatings, zwitterionic polymers, and dynamic self-cleaning layers have shown promise in mitigating foulant adhesion and enhancing membrane durability [20]. For sustainable biofouling control, membrane functionalization with metal nanoparticles (Ag, CuO) or biocidal compounds has been extensively explored. Nevertheless, these approaches confront three fundamental limitations: (1) Metal nanoparticles often leach over time due to weak interfacial adhesion, compromising long-term antimicrobial efficacy [15]. (2) Leached nanoparticles may pose ecological risks, particularly in aquatic systems where they can disrupt microbial ecosystems [21,22]. (3) Synthetic antimicrobial agents undergo structural degradation under operational conditions (pH fluctuations, chlorine exposure), significantly reducing their effective service lifespan. Thus, achieving a balance between fouling resistance, structural stability, and separation performance remains a critical research frontier in advancing functional LNF membranes. The synergistic optimization of pore size and surface charge distribution represents a critical strategy for developing high-performance nanofiltration membranes with superior dye/salt separation capabilities. The strategic selection of separation layer materials coupled with enhanced biofouling resistance constitutes equally critical design for developing durable LNF membranes.
Lysozyme (Lys) is a kind of natural antibacterial protein that is confirmed for use in food by the Food and Drug Authority (FDA) [23]. It has a promising antibacterial performance in the medical and food industries. Lys has also been used in a membrane filtration process, such as in enzymatic cleaning [24]. However, these approaches can have several challenges, including complex and harsh synthesis conditions, low durability, and other problems. Within this context, the immobilization of Lys on the membrane surface will be a potential way to reduce the cost and improve its biofouling-resistant efficiency. Tannic acid (TA), a natural polyphenol consisting of abundant phenolic hydroxyl groups in one molecule, can bind tightly to biopolymers such as proteins and some polysaccharides through non-covalent interactions (e.g., hydrogen bonding and hydrophobic interactions) and is, therefore, widely used in membrane preparation [25]. TA and lysozyme carry opposite charges, leading to electrostatic repulsion between them and foulants with similar charges. This repulsion prevents the foulants from attaching to the membrane surface. Furthermore, a prior study elucidated that Lys and TA can be easily cross-linked together to fabricate a biofouling-resistant implant via the LBL method [26]. The TA and Lys assembly provides a protective barrier, minimizes pore blockage, repels foulants electrostatically, and increases the hydrophilicity of the membrane surface. To the best of our knowledge, there have been no reports on TA-Lys-modified antifouling LNF membranes for dye/salt separation.
In this study, we developed a multilayer layer-by-layer (mLBL) assembly approach to construct antifouling PES/Fe-TA-Lys LNF membranes by strategically leveraging TA’s dual functionality in metal coordination and lysozyme binding. TA was first immobilized on the iron complexes blended with a PES (PES/Fe) ultrafiltration membrane by the coordination with Fe3+, followed by the formation of a TA-Lys composite layer via biocompatible coating to obtain the PES/Fe-TA-Lys LNF membrane. The preparation process of the LNM is shown in Figure 1. The density and thickness of the separation layer were precisely controlled by adjusting the assembly time. The morphology, surface charge, permeability, and dye/salt separation performance were investigated in detail. The antifouling performance of prepared membranes was determined using bovine serum albumin (BSA), humic acid (HA), and Congo Red (CR) as model organic pollutants, and Escherichia coli (E. coli) and Pseudomonas aeruginosa (P. aeruginosa) as model microorganisms. This work gives a green and energy-saving strategy to prepare a perm-selective nanochannel layer for dye/salt separation and antifouling.

Figure 1.
Schematic diagram of preparing the PES/Fe-TA-Lys membranes.
2. Materials and Methods
2.1. Chemicals and Materials
Tannic acid (TA), iron (III) acetylacetonate (Fe(acac)3), and lysozyme from chicken egg white (Lys, ≥20,000 U/mg) were purchased from Aladdin Reagent Co., Ltd. (Shanghai, China). Polyethersulfone (PES, Ultrason E6020P, Mw = 58 kDa) was obtained from BASF (Germany). Polyvinylpyrrolidone (PVP) and N, N-dimethyl formamide (DMF), Congo Red (CR), Methyl blue (MB), Eriochrome Black T (EBT), Acid Orange74 (AO 74), humic acid (HA), magnesium chloride (MgCl2), magnesium sulfate (MgSO4), sodium sulfate (Na2SO4), sodium chloride (NaCl), and bovine serum albumin (BSA) were purchased from Sinopharm Chemical Reagent Co., Ltd. (Shanghai, China).
2.2. Preparation of the PES/Fe Membranes
The PES/Fe membranes were prepared via a nonsolvent-induced phase separation (NIPS) method. In details, PES (16%), PVP (8%), and Fe(acac)3 (1.5%) were dispersed in DMF (78.8%) solution and stirred at 60 °C for 6 h to obtain a uniform casting solution. The PVP was used as a pore-forming agent. The casting solutions were stored at room temperature for 12 h to ensure a complete release of bubbles and then cast on a non-woven support using an automated film applicator with a gap of 320 μm. Subsequently, the cast films were immersed into a coagulation bath at room temperature after being exposed to the atmosphere for 20 s. Then, the prepared membranes were immersed in pure water for at least 24 h to leach out the residual solvent before testing. This preparation process is consistent with the method in our previous research [27].
2.3. Preparation of the PES/Fe-TA-Lys Membranes
First, the PES/Fe membranes were immersed in TA solution (5 g/L) and shaken at 25 °C for 1 h to obtain PES/Fe-TA1 membranes. Then, the PES/Fe-TA1 membrane was thoroughly cleaned with deionized water to remove unreacted TA on the membrane surface. Then, the PES/Fe-TA1 membranes were immersed in lysozyme solution (1.0 g/L) and shaken at 25 °C for 1 h to obtain PES/Fe-TA1-Lys1 membranes. The above soaking and cleaning steps were repeated to obtain the PES/Fe-TAn-Lysn LNF membrane with the outermost layer of Lys. Finally, the obtained membrane was stored in deionized water before use.
2.4. Characterization of Membranes
The chemical structures and elemental compositions of the membranes were analyzed by Fourier transform infrared spectroscopy (ATR-FTIR, Nicolet 6700, TMO, Waltham, MA, USA) and X-ray photoelectron spectroscopy (XPS, Thermo Fisher Scientific Escalab 250 Xi, Waltham, MA, USA), respectively. The field emission scanning electron microscope (FESEM, Hitachi S-4800, Tokyo, Japan) was operated to characterize the morphology of the membranes. Prior to observing the surface morphological characteristics of the membrane, the samples underwent the following pretreatment steps: First, the membrane was dried using a supercritical drying apparatus. The dried membrane was then cut into appropriately sized pieces and mounted on the sample stage with conductive adhesive. Finally, the samples were sputter-coated with gold to ensure conductivity before SEM analysis. The hydrophilicity of these membranes was characterized by a contact angle goniometer (SL-200C, KINO, Boston, MA, USA) using DI-H2O as a probe liquid. The surface zeta potentials of the membranes were determined by a Sur-PASS electrokinetic analyzer (SurPASS, Anton Paar GmbH, Graz, Austria).
2.5. Performance of Nanofiltration Membranes
The NF experiments were tested by self-made cross-flow flat membrane cells with an effective area of 7.065 cm2 at room temperature. The membranes were initially compacted for 20 min under 3 bar to obtain a steady permeation, and then the pressure was lowered to 2 bar. The water flux (J, L·m−2·h−1) was measured and calculated by the following equation:
where V (L) is the volume of permeated water, A (m2) is the effective membrane area, and Δt (h) is the permeation time.
The rejection performance of these NF membranes was conducted by using single-component salt solution (1 g/L Na2SO4, MgSO4, MgCl2, and NaCl) and dye solution (0.1 g/L CR, MB, EBT, and AO 74) as feed solution, respectively. Furthermore, the separation performance of PES/Fe-TA-Lys composite membrane for a dyeing salt mixed system was investigated with different dyes and NaCl solutions. The concentration of fixed dye was 0.1 g/L, the concentration of salt solution was 1 g/L, and the operating pressure was 2 bar. The volume of the feed solution used to perform the filtration experiments was 2 L, and the cross-flow filtration system was operated in recirculation mode. The rejection ratio (R) was defined as in the following equation:
where Cp and Cf were the concentration of permeate and feed solution, respectively. Herein, the salt concentration was measured by an electrical conductivity meter (FE38, METTLER TOLEDO, Shanghai, China). The dye concentration was measured by a UV–vis spectrophotometer (UV-7504PC, XINMAO, Shanghai, China).
2.6. Antifouling Performance Measurement and Long-Term Stability Test
The antifouling measurements of the PES/Fe-TA-Lys membranes were conducted using CR, BSA, and HA as a representative pollutant. The foulant concentrations in feed solutions were 0.1 g/L. The antifouling testing was conducted under 2 bar and the process is as follows: Firstly, the membrane sample was pressurized to reach a stable water flux before the measurement. Then, the pure water flux was continuously measured for 60 min and recorded every 10 min as Jw1. Afterwards, the membrane filtration was conducted using CR solution as feed for another 60 min. The permeate flux was also tested every 10 min and recorded as Jp. Later, the membrane after filtering the CR solution was simply cleaned using deionized water for 30 min. Subsequently, the pure water flux was measured again and recoded as Jw2 for 60 min. The operations for BSA and HA antifouling were similar to the above process using BSA or HA solution as the feed solution, respectively. Lastly, the antifouling performance was evaluated by flux recovery ratio (FRR), total fouling ratio (Rt), reversible fouling ratio (Rr), and irreversible fouling ratio (Rir). Those parameters were defined and calculated as follows.
The CR (0.1 g/L) solutions mixed with NaCl (1 g/L) were used as feed solution to conduct the long-term stability measurement (24 h) on the optimized the PES/Fe-TA-Lys membrane.
2.7. Biofouling Resistance Evaluation of the PES/Fe-TA-Lys Membranes
2.7.1. Biofouling Resistance Assessment
To evaluate the biofouling resistance of the membrane, Escherichia coli (E. coli) and Pseudomonas aeruginosa (P. aeruginosa) were used as bacterial models. The anti-biofouling performance was quantified by calculating the bacterial inhibition rate (%) using colony-forming unit (CFU) counts on LB agar plates. All experimental materials (e.g., membranes, culture vessels) were sterilized via autoclaving at 120 °C for 30 min prior to use.
Bacterial activation and culture: Take a small bacterial colony from the bacterial strains stored in the refrigerator, place it in 100 mL of liquid culture medium, activate and cultivate it in a constant temperature shaker at 37 °C for 12–16 h, and then, after the above-mentioned culture, add 1 mL of the first-generation bacteria solution to 100 mL of liquid culture medium, and continue culturing for 12–16 h at 37 °C in a constant temperature shaking box to obtain the second-generation bacteria.
Antibacterial contact assay: Three membrane samples of PES/Fe membrane, PES/Fe-TA, and PES/Fe-TA-Lys membranes were cut out with a diameter of 4.0 cm. Secondary cultures of E. coli and P. aeruginosa were diluted in phosphate-buffered saline (PBS, pH 7.4) and adjusted to a final concentration of 1 × 107 CFU/mL. Each membrane sample was immersed in 100 mL of the standardized bacterial suspension within sterile Erlenmeyer flasks. Triplicate setups were incubated at 37 °C with continuous agitation (150 rpm) for 5 h to simulate dynamic biofilm formation conditions.
Diluted colony count: Take out the membrane sample, rinse with PBS sterile aqueous solution, and put it into 50 mL PBS sterile water. Then, employ ultrasonic treatment for 10 min to remove the bacteria attached to the membrane sample, serially dilute the bacterial suspension 1000 times, and take 50 μL of the diluted solution and spread it evenly on the agar plate. Then, count the bacteria after 24 h incubation at 37 °C. The experiment was repeated three times for each kind of membrane. The bacterial adhesion reduction rate of the membrane against bacteria is calculated with the following formula:
where G is the attachment ratios of the membrane against bacteria (%); N1 is the number of colonies in the blank membrane experiment; and N2 is the number of colonies in the membrane experiment.
For SEM observation of bacterial morphologies, membrane samples exposed to E. coli and P. aeruginosa were first fixed with 2.5% glutaraldehyde in PBS (pH 7.4) for 4 h at 4 °C. The samples were then dehydrated using a graded ethanol series (30%, 50%, 70%, 90%, and 100% v/v, 15 min each) and dried overnight in a desiccator. Prior to imaging, the samples were sputter-coated with gold to enhance conductivity.
2.7.2. Anti-Biofouling Activity in a Crossflow Membrane Filtration Process
A dynamic biofouling-resistant experiment was carried out in a cross-flow filtration device to evaluate the performance of the PES/Fe-TA-Lys membrane against E. coli and P. aeruginosa. The effective area of the membrane is 7.065 cm2. Before the cross-flow biofouling-resistant experiment, the entire cross-flow device was cleaned and disinfected with 75% ethanol for 30 min, and then the device was cleaned three times with sterile water. The bacterial solution diluted to a certain multiple was taken as the filtering solution. It was operated at 0.2 MPa, the temperature was kept constant at 25 ± 1 °C, and the change in the membrane permeation flux was recorded with the time of filtering the bacterial solution.
3. Results and Discussion
3.1. The Physicochemical Characterization
Figure 2a shows the FTIR spectra of the PES/Fe, PES/Fe-TA, and PES/Fe-TA-Lys membranes, respectively. The FTIR spectra of PES/Fe and PES/Fe-TA membranes are consistent with our previous research [27]. It can be seen that a new stretching vibration peak at 1717 cm−1 appears in the PES/Fe-TA membrane, which was assigned to the -C=O- bonds in TA [28]. The PES/Fe-TA-Lys membrane has a reduced stretching vibration peak here, which may be due to the reaction of TA and Lys. In addition, the broad stretch peak in the wavelength range of 3100–3600 cm−1 is caused by the vibration of the phenolic hydroxyl -OH functional group in the TA structure [29]. Compared with the PES/Fe membrane and PES/Fe-TA membrane, the PES/Fe-TA-Lys membrane has a larger stretching vibration peak at 3400 cm−1, which is due to the increase in -OH content on the membrane surface due to the addition of TA and Lys [30]. These spectroscopic observations conclusively demonstrate the successful assembly of TA and Lys on the PES/Fe membrane surface.

Figure 2.
(a) FTIR spectra and (b) XPS spectra of the PES/Fe, PES/Fe-TA, and PES/Fe-TA-Lys membranes.
XPS analysis was conducted to further characterize the surface element composition of the membranes, and the result is shown in Figure 2b. The XPS spectra revealed consistent C 1s, N 1s, and O 1s peak profiles across all membrane samples. The quantitative analyses were made on the change in the element content of the three membranes (Table 1). The PES/Fe-TA membrane exhibited significantly higher oxygen content (25.21%) compared to the PES/Fe membrane (18.55%), with a 6.66% absolute increase. This enhancement directly corresponds to TA’s abundant phenolic hydroxyl groups, confirming successful surface incorporation. N element appeared on the surface of the PES/Fe and PES/Fe-TA membrane, which may be ascribed to the residues of PVP additive used in membrane fabrication, which is consistent with results in our previous study [27]. It is worth noting that N content rises from 3.56% (PES/Fe-TA) to 10.25% (PES/Fe-TA-Lys), accompanied by a corresponding decrease in the O/N atomic ratio from 7.08 to 2.57. The 2.9-fold increase in N content directly evidences successful Lys anchoring. And, the reduced O/N ratio reflects the expected chemical composition of Lys (theoretical O/N ≈ 2.0). The quantitative changes in surface elemental composition provide direct evidence for successful TA-Lys layer formation, in full agreement with FTIR spectroscopic observations.

Table 1.
The element content of various membranes.
To further prove the introduction of TA and Lys on membrane surfaces, high-resolution XPS analysis was conducted on C 1s and N 1s core-level spectra across three membrane variants (Figure 3). The PES/Fe membrane has two main peaks at 284.6 eV and 286.3 eV, corresponding to C-C and C-O groups, respectively (Figure 3a). A new peak appeared in the PES/Fe-TA membrane at 287.5 eV (Figure 3b), which is the peak corresponding to the ester group C=O in TA, indicating that TA has been successfully introduced onto the surface of the film [19]. In contrast, the PES/Fe-TA-Lys membrane has a new peak at 285.6 eV (Figure 3c), which is contributed by the C-S in the Lys structure [31]. To further prove the introduction of Lys, the N 1s peaks of the three membranes were analyzed in detail. As shown in Figure 3d–f, compared with the PES/Fe membrane and PES/Fe-TA membrane, the PES/Fe-TA-Lys membrane has a new peak at 401.7 eV, which corresponds to the -NH3+ functional group. -NH3+ is provided by arginine and lysine residues in lysozyme [32]. This further shows that the surface of the PES/Fe-TA-Lys membrane is covered by lysozyme.

Figure 3.
XPS spectra of C 1s (a–c) and N 1s (d–f) of the PES/Fe, PES/Fe-TA, and PES/Fe-TA-Lys membranes.
The evolution of surface wettability during the layer-by-layer assembly process was quantitatively monitored through static water contact angle (WCA) measurements, as systematically depicted in Figure 4. Initial PES/Fe substrates exhibited regular hydrophilicity (WCA = 76.4° ± 1.3°), characteristic of sulfone-containing polymer matrices [33]. The subsequent in situ deposition of a TA monolayer via FeIII-phenolic coordination dramatically enhanced surface hydrophilicity (ΔWCA = −26.2°), achieving a WCA of 50.2° ± 0.8°. This is due to the large number of hydrophilic phenolic hydroxyl groups in the TA molecule, which establish extensive hydrogen-bonding networks with water molecules through their ortho-dihydroxyphenyl moieties. Intriguingly, the covalent immobilization of Lys through Schiff base/Michael addition reactions induced a controlled hydrophobic shift (WCA = 55.8° ± 1.1°), representing a 11.2% reduction in WCA compared to TA-modified surfaces. However, after assembling a layer of Lys, the contact angle of the membrane increased slightly, which may be due to the covalent reaction between TA and Lys. In addition, lysozyme itself is hydrophobic, which changes the hydrophilicity of the hybrid membrane. Notably, the hierarchical assembly process maintains overall hydrophilicity (WCA < 60°), with cumulative WCA changes limited to 10.6° across three modification stages. This controlled wettability modulation demonstrates the precision of bio-inspired surface engineering in balancing hydration capacity and biofouling resistance, crucial for nanofiltration applications requiring both high flux and selective separation.

Figure 4.
Water contact angle of membranes as a function of layer number.
The pH-dependent surface charge evolution of the membrane series was systematically probed through zeta potential analysis (pH 3–10), revealing distinct interfacial chemistry modulation by hierarchical functionalization (Figure 5). The pristine PES/Fe membrane exhibited amphoteric characteristics with an isoelectric point (IEP) at pH 4.2 ± 0.3, typical of sulfonated polymer surfaces [34]. The PES/Fe-TA membrane exhibited significantly stronger surface electronegativity compared to the PES/Fe membrane, which can be attributed to the abundance of phenolic hydroxyl groups in TA molecules. These functional groups undergo deprotonation to release hydrogen ions, thereby imparting negative charges to the membrane surface [22]. As the pH increases, the progressive deprotonation of phenolic hydroxyl groups enhances this negative surface charge [35]. Notably, the PES/Fe-TA-Lys membrane retained pronounced electronegativity even after Lys functionalization. This retention of negative charge can be attributed to two synergistic effects: (1) Persistent unreacted phenolic hydroxyl groups from TA on the membrane surface undergo continuous deprotonation, sustaining their contribution to surface electronegativity. (2) Lysozyme’s inherent ionizable functional groups, such as carboxyl (–COOH) and amine (–NH2) groups, exhibit pH-responsive behavior. Under alkaline conditions, carboxyl groups deprotonate (–COO−), while amine groups remain protonated (–NH3⁺), collectively amplifying the net negative charge. This dynamic ionization process drives the steep pH-dependent decrease in surface potential observed across the tested pH range.

Figure 5.
Zeta potentials of the PES/Fe, PES/Fe-TA, and PES/Fe-TA- Lys membranes at different pH.
3.2. Effect of Layer Number on the Membrane Properties
The nanoscale architecture of composite membranes was strategically engineered through the precise control of layer-by-layer (LbL) assembly cycles (n = 1–6), establishing quantitative structure–performance relationships. Figure 6 presents the membrane surface and cross-sectional SEM morphologies with varying numbers of assembled layers. The surface images (Figure 6a–f) reveal a progressive reduction in pore density as the layer count increases, culminating in a nearly nonporous surface morphology at six layers. This transition correlates with the formation of a rough and densely packed surface structure, indicative of a newly established separation layer. Cross-sectional analysis (Figure 6(a1–f1)) further demonstrates a linear increase in the separation layer thickness from 56 nm (single layer) to 186 nm (six layers), directly proportional to the assembly cycles. Collectively, these structural evolutions confirm the successful layer-by-layer deposition of TA and Lys, resulting in a continuous and defect-free active layer critical for enhanced separation performance.

Figure 6.
SEM analysis of the top surface (a–f) and cross-section (a1–f1) morphologies of PES/Fe-TA and PES/Fe-TA-Lys membranes.
The filtration performance results of membranes with different numbers of assembled layers are shown in Figure 7. Pure water flux decreased exponentially from 264 L·m−2·h−1 (1 layer) to 57 L·m−2·h−1 (6 layers), reflecting progressive active layer densification. The rejection rate of CR by the LNF membrane increased from 86.6% to 98.7%. This improvement is attributed to the assembly of TA and Lys, which forms a thicker and denser active layer on the membrane surface and enhances its negative surface charge. The combined effects of electrostatic repulsion and size exclusion contribute to the enhanced retention of the anionic dye CR. Comprehensively considering the water flux and dye rejection, the assembly layer was four layers in the following experiments. The pure water permeability of the nanofiltration membrane prepared under this condition was 115 L∙m−2∙h−1, and the rejection rate of CR was 98.3%.

Figure 7.
The pure water flux and CR rejection of PES/Fe-TA-Lys membranes with different layer numbers.
3.3. Filtration Performance
To further explore the NF separation performance, CR, MB, EBT, and AO 74 were selected as representative dyes for the separation performance test of a single component, and the results are shown in Figure 8. The permeation fluxes of the PES/Fe-TA-Lys loose nanofiltration membrane to the CR, MB, EBT, and AO 74 were 74.6 L∙m−2∙h−1, 61.5 L∙m−2∙h−1, 63.6 L∙m−2∙h−1, and 93.8 L∙m−2∙h−1; the corresponding rejection rates were 98.3%, 99.2%, 98.4%, and 67.6%, respectively. The difference in the retention performance of dyes with different molecular weights can be explained by the pore size screening effect. Compared with the AO 74 with smaller relative molecular weights, CR, MB, and EBT have larger relative molecular weights (696.66, 799.80, and 461.38, respectively). The space resistance will be greater when passing through the membrane, which makes it easier to be intercepted by the dense membrane pores [11]. At the same time, the charge repulsion effect will also affect the dye retention effect. For example, although the molecular weight of CR is smaller than that of MB, the prepared loose nanofiltration membrane has a higher rejection rate of CR than that of MB, which is mainly due to the high negative charge of CR and the agglomeration effect [36].

Figure 8.
Separation performance of PES/Fe-TA-Lys membranes for different dyes.
As shown in Figure 9, the PES/Fe-TA-Lys LNF membrane has a relatively low rejection rate of the four inorganic salts (R < 10%), and the retention performance order is Na2SO4 (8.2%) > MgSO4 (4.3%) > NaCl (3.5%) > MgCl2 (2.4%), consistent with its design as an LNF membrane. This behavior primarily resulted from Donnan exclusion. The negatively charged membrane surface (confirmed by zeta potential measurements) effectively repelled sulfate anions (SO42−), leading to higher Na2SO4 rejection compared to chloride salts. The divalent SO42− experienced stronger electrostatic repulsion than monovalent Cl−, explaining the observed retention order between sulfate and chloride salts [37]. On the contrary, Mg2+ more easily penetrates the membrane pores than Na+ [38]. Therefore, among the four inorganic salts, the rejection rate of MgCl2 is the lowest, while the rejection rate of Na2SO4 is the highest. Considering this comprehensively, the PES/Fe-TA2-Lys2 LNF membrane has a high rejection rate of CR (98.3%), a low rejection rate of NaCl (3.5%), a high dye rejection rate, and a low salt rejection rate. It shows the separation performance of a typical loose nanofiltration membrane, and has potential application prospects in dye desalination.

Figure 9.
Separation performance of PES/Fe-TA2-Lys2 membranes for different salt solutions.
The dye/salt fractionation capability of the PES/Fe-TA-Lys LNF membrane was systematically evaluated under varying Congo Red (CR) concentrations (0.1–0.5 g/L) in mixed NaCl solutions (1 g/L), as demonstrated in Figure 10. The CR rejection efficiency exhibited a logarithmic increase from 97.3% to 99.6%, while NaCl rejection rose linearly from 3.1% to 4.47%. This was primarily ascribed to the fact that the CR dye molecules with a higher concentration tend to form a denser fouling layer as additional resistance on the membrane surface. In addition, the negatively charged CR dye is adsorbed on the surface of the membrane, which enhances the negative charge of the membrane surface, thereby promoting the retention of CR and NaCl [39,40,41]. Furthermore, the flux declined from 74.6 L∙m−2∙h−1 to 64.1 L∙m−2∙h−1, which was due to the reverse osmosis pressure generated by the dye concentration difference across the membrane and dye adsorption into the membrane pore. In summary, the higher rejection rate of dye and the lower rejection rate of inorganic salt indicate that the prepared PES/Fe-TA-Lys LNF membrane can be applied to dye desalination.

Figure 10.
Effect of different CR concentrations in dye/salt mixture solution on separation performance of PES/Fe-TA-Lys membrane.
The filtration performance of the PES/Fe-TA2-Lys2 membrane was evaluated across a range of pH values (4–10), and the results are presented in Figure S3. Under acidic conditions (pH 4), the permeation flux exhibited a slight decrease, dropping from 74 L·m−2·h−1 at neutral pH to 72.3 L·m−2·h−1. The dye rejection rate remained stable at approximately 98.7%, while the NaCl rejection rate was maintained at 3.8%. This phenomenon can be attributed to the accumulation of charged ions on the membrane surface under acidic conditions, exacerbating concentration polarization and increasing mass transfer resistance. This, in turn, resulted in a modest decline in permeation flux, while the dye rejection rate remained consistent. In contrast, significant performance changes were observed under alkaline conditions. At pH 10, the permeation flux increased from 74 L·m−2·h−1 to 88.3 L·m−2·h−1, while the CR rejection rate decreased significantly to 94.1%. This is because the lysozyme component within the membrane material dissolved under alkaline conditions, leading to the micro-dissolution of the separation layer. This resulted in larger pore sizes, increased flux, and decreased dye rejection.
3.4. Antifouling Properties and Long-Term Stability
In order to explore the anti-pollution ability of the PES/Fe-TA-Lys loose nanofiltration membrane, CR, BSA, and HA solutions (0.1g/L) were selected as typical pollutants, and the filtration experiment was carried out at 0.2 MPa. As shown in Figure S1a, the water flux of the PES/Fe-TA-Lys loose nanofiltration membrane over time was tested. In the initial stage of filtering pure water, the water flux remains basically unchanged. During the filtering of the pollutant solution, the membrane was polluted by three pollutants to different degrees, and the water flux dropped sharply to a stable stage. The initial flux decline observed within 1 h is primarily attributed to the rapid adsorption of foulants (e.g., BSA, HA, CR) onto the membrane surface and pore blockage, which is a common phenomenon in membrane filtration [42]. Then, after a simple rinse with pure water for 30 min, the water flux of the membrane returned to a different level, was greatly improved, and then remained stable. The subsequent flux recovery after water rinsing demonstrates the reversible nature of the fouling, facilitated by the membrane’s hydrophilic and negatively charged surface, which weakens foulant adhesion [43]. Due to the hydrophilicity of the membrane surface and high affinity with water molecules, the dirt layer deposited during the cleaning process is easily washed away [44].
Additionally, as shown in Figure S1b, the antifouling indices of the PES/Fe-TA-Lys loose nanofiltration membrane against various pollutants were also calculated and presented. The FRR values of CR, BSA, and HA are 90.7%, 86.4%, and 91.7%, and the corresponding Rt values are 41.9%, 55.1%, and 38%. The flux recovery rate of the HA solution is higher than that of the CR and BSA solutions. This can be explained by the strong electrostatic repulsion between HA molecules and the membrane surface. The high negative charge characteristics of HA pollutants (−41.6 Mv) can effectively alleviate the deposition of HA molecules on the membrane surface or the formation of pollution layers during the filtration process, while the less negatively charged BSA solution (−9.8 Mv) may cause slightly higher levels of dirt to be formed. In addition, the smaller particle size of BSA molecules (7.5 nm (BSA) < 92 nm (HA)) more easily forms a dense pollution layer on the surface of the membrane [11]. Therefore, the pollution of BSA is more serious, and it is difficult to remove BSA pollutants on the membrane surface through hydraulic cleaning. Based on the above results, because the PES/Fe-TA-Lys loose nanofiltration membrane has higher hydrophilicity and lower surface negative charge, these properties are beneficial to reduce the adhesion of pollutants, which proves that the prepared loose nanofiltration membrane has good antifouling performance.
In order to determine the practical applicability of the PES/Fe-TA-Lys LNF membrane in dye/salt separation, we used a mixed solution of 0.1 g/L CR and 1 g/L NaCl to investigate the long-term operational stability of the membrane. As shown in Figure 11, the permeation flux dropped from 74 L∙m−2∙h−1 to 62 L∙m−2∙h−1 in the first 6 h, which may be due to the adsorption behavior of the dye on the membrane surface [45]. However, because the prepared PES/Fe-TA-Lys loose nanofiltration membrane has excellent antifouling performance, after about 9 h, the adsorption establishes a dynamic equilibrium, and the permeation flux only slightly changes (about 57.2 L∙m−2∙h−1). In addition, during the 24h filtration process, the rejection rate of CR can be maintained above 97.9%, the rejection rate of NaCl is below 4.8%, and the separation efficiency of dye/salt is maintained at a high level. The results show that the optimized PES/Fe-TA-Lys loose nanofiltration membrane has good long-term stability, which promotes its further practical application in dye wastewater treatment.

Figure 11.
The long-term operation stability of PES/Fe-TA-Lys membranes for the CR/NaCl mixture solution (0.1 g/L CR and 1 g/L NaCl).
The separation performance of the PES/Fe-TA-Lys membrane developed in this work was systematically benchmarked against state-of-the-art loose nanofiltration membranes (Table S2). Comparative analysis revealed that the PES/Fe-TA-Lys membrane showed relatively high permeate flux and high rejection for dyes as well as low salt rejections in comparison with the listed membranes.
3.5. Biofouling Resistance and Biofilm-Inhibiting Properties of the PES/Fe-TA-Lys Membranes
According to the steps described in the experimental part, the prepared PES/Fe-TA-Lys loose nanofiltration membrane was compared with PES/Fe and PES/Fe-TA membranes in biofouling-resistant properties. As shown in Figure 12a, the number of bacterial colonies on the membrane reflects their biofouling-resistant properties. By defining the proportion of bacterial cells adhered to the surface of the PES/Fe membrane as 100%, the total proportion of bacterial cells attached to the PES/Fe-TA membrane and PES/Fe-TA-Lys loose nanofiltration membrane was calculated, as shown in Figure 12b. Compared with the PES/Fe membrane, the total number of attached cells in the PES/Fe-TA membrane is slightly reduced (the attachment ratios of E. coli and P. aeruginosa are 57.1% and 61.7%, respectively). This is due to the presence of TA on the surface of the PES/Fe-TA membrane. The unreacted phenolic hydroxyl group in TA may have an inhibitory effect on bacteria, thus giving the film weak biofouling-resistant properties. On the other hand, the proportion of E. coli and P. aeruginosa on the surface of the PES/Fe-TA-Lys loose nanofiltration membrane was significantly reduced to 6% and 8.3%, respectively. This is attributed to the hydrophilic and negatively charged characteristics of the PES/Fe-TA-Lys loose nanofiltration membrane. The hydrated layer on the surface of the membrane acts as a protective layer to prevent direct contact between bacteria and proteins. At the same time, lysozyme is a kind of hydrolytic enzyme, which is characterized by its ability to cleave the β-(1, 4)-glycosidic bond between N-acetylmuramic acid and N-acetylglucosamine in peptidoglycan, the major and unique bacterial cell wall biomacromolecule [23]. Therefore, the PES/Fe-TA-Lys loose nanofiltration membrane prepared by layer-by-layer self-assembly has strong biofouling-resistant properties against E. coli and P. aeruginosa.

Figure 12.
(a) The photographs of growing viable colonies of E. coli and P. aeru and (b) the fraction of bacteria attached to the membrane surface.
As shown in Figure S2, a dynamic biofouling-resistant experiment was carried out through a cross-flow filtration device to evaluate the inhibitory performance of the PES/Fe-TA-Lys loose nanofiltration membrane against E. coli and P. aeruginosa. It can be seen that, in the cross-flow filtration of E. coli, the initial flux of PES/Fe membrane and PES/Fe-TA membrane dropped sharply due to biological contamination, and dropped by 82% and 67%, respectively, after 180 min of filtration. Under the same conditions, with the cross-flow filtration of P. aeruginosa, the permeation flux decreased by 88% and 71%, respectively. This is mainly due to the instantaneous deposition of bacteria on the surface of the membrane, and the bacteria growing on the membrane block the surface pores. In contrast, the PES/Fe-TA-Lys loose nanofiltration membrane has a smaller flux drop, and the filtration of E. coli and P. aeruginosa drops by 38% and 42%, respectively. This shows that, compared with the PES/Fe membrane and PES/Fe-TA membrane, the PES/Fe-TA-Lys loose nanofiltration membrane has better biofouling resistance, attributed to its hydrophilic surface, negative charge, and lysozyme-mediated biofilm disruption. The surface of the PES/Fe-TA-Lys loose nanofiltration membrane has a strong negative charge, which can limit the adhesion of bacteria through electrostatic repulsion, and the surface hydrophilicity can further enhance the resistance to organisms by preventing the adhesion of bacteria on the surface of the membrane.
To further verify the anti-biological contamination activity of the PES/Fe-(TA-Lys)4 sparse nanofiltration membrane, the bacterial morphology on the contaminated membrane was observed via scanning electron microscopy. As shown in Figure 13, E. coli and P. aeruginosa were almost completely covered on the surface of PES/Fe and PES/Fe-TA membranes (as a control), and it could be observed that the bacterial cells on the surface of the membranes showed normal morphology. However, the number of attached bacteria on the PES/Fe-TA2-Lys2 sparse nanofiltration membranes was much less than the other membranes. Moreover, it was observed that the bacterial cells on the PES/Fe-TA2-Lys2 sparse nanofiltration membrane showed deformation and collapse. This result further confirmed that the PES/Fe-TA2-Lys2 sparse nanofiltration membrane can effectively inhibit the viability of bacteria and, thus, reduce biological contamination.

Figure 13.
SEM images of bacterial morphologies (E. coli and P. aeru) on the membranes.
4. Conclusions
This work pioneers a bioinspired LNF membrane for efficient dye/salt separation with integrated biofouling-resistant/antifouling functionalities, engineered via a three-stage fabrication protocol: (1) An iron-acetylacetonate-blended PES ultrafiltration substrate (PES/Fe) was formed through non-solvent-induced phase separation. (2) TA was deposited via FeIII-phenolic coordination. (3) Lys was covalently conjugated through Schiff base/Michael addition reactions. Through the systematic optimization of the assembly layers, the resulting LNF membrane achieves an optimal balance between high permeability and exceptional selectivity. The optimized PES/Fe-TA-Lys membrane demonstrated outstanding dye rejection rates of 98.3% (CR), 99.2% (MB), 98.4% (EBT), and 67.6% (AO74), while maintaining low salt retention (Na2SO4: 8.2%; MgSO4: 4.3%; NaCl: 3.5%; MgCl2: 2.4%). The membrane exhibited a pure water flux exceeding 57.5 L·m−2·h−1 and maintained stable performance during 24 h continuous operation. At the same time, the membrane showed excellent antifouling properties against BSA, HA, and CR, along with effective biofouling resistance against E. coli and P. aeruginosa, primarily mediated by surface hydrophilicity, electrostatic repulsion, and lysozyme-assisted biofilm inhibition. These results substantiate the significant potential of the biofouling-resistant PES/Fe-TA-Lys LNF membrane in textile wastewater treatment, particularly for industrial-scale applications demanding high-efficiency dye/salt fractionation.
Supplementary Materials
The following supporting information can be downloaded at: https://www.mdpi.com/article/10.3390/separations12050129/s1, Figure S1: Membrane fouling during filtration of CR, BSA and HA solution with PES/Fe-TA-Lys membranes: (a) normalized flux, (b) antifouling indexes; Figure S2: The normalized water flux of the PES/Fe, PES/Fe-TA, and PES/Fe-TA-Lys membranes during the (a) E. coli and (b) P. aeru biofouling experiment; Figure S3: water permeance and rejection of the PES/Fe-(TA-Lys)4 membrane at different pH values. Table S1: Information on different dyes; Table S2: The separation performance of PES/Fe-(TA-Lys)4 prepared in this work and other literatures for CR/NaCl solution (details). References [23,46,47,48,49,50,51,52,53,54,55,56] are cited in the Supplementary Materials.
Author Contributions
Conceptualization, X.F., J.Y. and F.L.; methodology, J.Y., S.L., F.L. and X.Y.; experiments and characterizations, S.L. and X.Y.; original draft, X.Y.; reviewing and editing, J.Y., X.F., M.S. and Y.H.; data curation, X.Y. and S.L.; funding acquisition, Y.H., F.L. and X.F. All authors have read and agreed to the published version of the manuscript.
Funding
This work was supported by “Lingyan” R&D Plan Project of Zhejiang Province (2024C03284(SD2)), the National Natural Science Foundation of China (No. 5240071), and the Fundamental Research Funds for the Central Universities (No. 2232024G-11).
Data Availability Statement
This study did not report any data in public datasets analyzed or generated.
Conflicts of Interest
The authors declare that they have no known competing financial interests or personal relationships that could have appeared to influence the work reported in this paper.
Correction Statement
Due to an editorial office error, Wei Huang was incorrectly listed as one of the two listed Academic Editors. This information has been updated and this change does not affect the scientific content of the article.
References
- Dasgupta, D.; Barman, S.; Sarkar, J.; Mridha, D.; Labrousse, P.; Roychowdhury, T.; Acharya, K.; Sarkar, J.; Chakraborty, N. Mycoremediation of different wastewater toxicants and its prospects in developing value-added products: A review. J. Water Process Eng. 2024, 58, 104747. [Google Scholar] [CrossRef]
- Waters, C.N.; Zalasiewicz, J.; Summerhayes, C.; Barnosky, A.D.; Poirier, C.; Galuszka, A.; Cearreta, A.; Edgeworth, M.; Ellis, E.C.; Ellis, M.; et al. The Anthropocene is functionally and stratigraphically distinct from the Holocene. Science 2016, 351, aad2622. [Google Scholar] [CrossRef] [PubMed]
- Lin, J.; Ye, W.; Xie, M.; Seo, D.H.; Luo, J.; Wan, Y.; Van der Bruggen, B. Environmental impacts and remediation of dye-containing wastewater. Nat. Rev. Earth Environ. 2023, 4, 785–803. [Google Scholar] [CrossRef]
- Sharma, J.; Sharma, S.; Soni, V. Classification and impact of synthetic textile dyes on Aquatic Flora: A review. Reg. Stud. Mar. Sci. 2021, 45, 101802. [Google Scholar] [CrossRef]
- Srivastava, A.; Rani, R.M.; Patle, D.S.; Kumar, S. Emerging bioremediation technologies for the treatment of textile wastewater containing synthetic dyes: A comprehensive review. J. Chem. Technol. Biotechnol. 2022, 97, 26–41. [Google Scholar] [CrossRef]
- Wu, S.-C.; Cheng, P.; Han, J.-J.; Chen, Y.; Yan, X.; Guo, X.-J.; Lang, W.-Z. Construction of two-dimensional Ag/WS2 hybrid membranes with self-cleaning ability by photocatalysis for efficient water filtration. J. Membr. Sci. 2022, 641, 119865. [Google Scholar] [CrossRef]
- Diawara, C.K. Nanofiltration Process Efficiency in Water Desalination. Sep. Purif. Rev. 2008, 37, 302–324. [Google Scholar] [CrossRef]
- Guo, S.; Wan, Y.; Chen, X.; Luo, J. Loose nanofiltration membrane custom-tailored for resource recovery. Chem. Eng. J. 2021, 409, 127376. [Google Scholar] [CrossRef]
- Ye, W.; Liu, H.; Lin, F.; Lin, J.; Zhao, S.; Yang, S.; Hou, J.; Zhou, S.; Van der Bruggen, B. High-flux nanofiltration membranes tailored by bio-inspired co-deposition of hydrophilic g-C3N4 nanosheets for enhanced selectivity towards organics and salts. Environ. Sci. Nano 2019, 6, 2958–2967. [Google Scholar] [CrossRef]
- Wang, K.; Wang, X.; Januszewski, B.; Liu, Y.; Li, D.; Fu, R.; Elimelech, M.; Huang, X. Tailored design of nanofiltration membranes for water treatment based on synthesis-property-performance relationships. Chem. Soc. Rev. 2022, 51, 672–719. [Google Scholar] [CrossRef]
- Yang, L.; Wang, Z.; Zhang, J. Zeolite imidazolate framework hybrid nanofiltration (NF) membranes with enhanced permselectivity for dye removal. J. Membr. Sci. 2017, 532, 76–86. [Google Scholar] [CrossRef]
- Van der Bruggen, B.; Curcio, E.; Drioli, E. Process intensification in the textile industry: The role of membrane technology. J. Environ. Manag. 2004, 73, 267–274. [Google Scholar] [CrossRef] [PubMed]
- Sajid, M.; Sajid Jillani, S.M.; Baig, N.; Alhooshani, K. Layered double hydroxide-modified membranes for water treatment: Recent advances and prospects. Chemosphere 2022, 287, 132140. [Google Scholar] [CrossRef]
- Li, X.; Liu, Y.; Wang, J.; Gascon, J.; Li, J.; Van der Bruggen, B. Metal-organic frameworks based membranes for liquid separation. Chem. Soc. Rev. 2017, 46, 7124–7144. [Google Scholar] [CrossRef] [PubMed]
- Lim, Y.J.; Goh, K.; Nadzri, N.; Wang, R. Thin-film composite (TFC) membranes for sustainable desalination and water reuse: A perspective. Desalination 2025, 599, 118451. [Google Scholar] [CrossRef]
- Ashraf, M.A.; Usman, M.; Hussain, I.; Ahmad, F.; Guo, S.W.; Zhang, L. Lithium extraction from high magnesium salt lake brine with an integrated membrane technology. Sep. Purif. Technol. 2022, 302, 122163. [Google Scholar] [CrossRef]
- Hu, Y.J.; Chen, Z.H.; Ding, Y.D.; Xu, Y.C.; Lin, H.J.; Yu, W.; Teng, J.H.; Shen, L.G.; Jiao, Y.; Liao, B.Q. Nanofiltration membranes fabricated by plant polyphenol-intermediated MXene and polyethyleneimine layer-by-layer self-assembly for efficient dye/salt separation. Sep. Purif. Technol. 2023, 323, 124343. [Google Scholar] [CrossRef]
- Denny, M.S.; Moreton, J.C.; Benz, L.; Cohen, S.M. Metal-organic frameworks for membrane-based separations. Nat. Mater. 2016, 1, 16078. [Google Scholar] [CrossRef]
- Huang, Z.; Ghasemi, H. Hydrophilic polymer-based anti-biofouling coatings: Preparation, mechanism, and durability. Adv. Colloid Interface Sci. 2020, 284, 102264. [Google Scholar] [CrossRef]
- Agrawal, A.; Sharma, A.; Awasthi, K.K.; Awasthi, A. Metal oxides nanocomposite membrane for biofouling mitigation in wastewater treatment. Mater. Today Chem. 2021, 21, 100532. [Google Scholar] [CrossRef]
- Jiang, S.; Qin, Y.; Yang, J.; Li, M.; Xiong, L.; Sun, Q. Enhanced antibacterial activity of lysozyme immobilized on chitin nanowhiskers. Food Chem. 2017, 221, 1507–1513. [Google Scholar] [CrossRef] [PubMed]
- Li, Y.; Luo, J.; Wan, Y. Biofouling in sugarcane juice refining by nanofiltration membrane: Fouling mechanism and cleaning. J. Membr. Sci. 2020, 612, 118432. [Google Scholar] [CrossRef]
- Li, Q.; Liao, Z.; Fang, X.; Wang, D.; Xie, J.; Sun, X.; Wang, L.; Li, J. Tannic acid-polyethyleneimine crosslinked loose nanofiltration membrane for dye/salt mixture separation. J. Membr. Sci. 2019, 584, 324–332. [Google Scholar] [CrossRef]
- Yang, S.; Wang, Y.; Wu, X.; Sheng, S.; Wang, T.; Zan, X. Multifunctional Tannic Acid (TA) and Lysozyme (Lys) Films Built Layer by Layer for Potential Application on Implant Coating. ACS Biomater. Sci. Eng. 2019, 5, 3582–3594. [Google Scholar] [CrossRef] [PubMed]
- Shen, Y.-J.; Fang, L.-F.; Yan, Y.; Yuan, J.-J.; Gan, Z.-Q.; Wei, X.-Z.; Zhu, B.-K. Metal-organic composite membrane with sub-2 nm pores fabricated via interfacial coordination. J. Membr. Sci. 2019, 587, 117146. [Google Scholar] [CrossRef]
- Xiao, Y.; Guo, D.; Li, T.; Zhou, Q.; Shen, L.; Li, R.; Xu, Y.; Lin, H. Facile fabrication of superhydrophilic nanofiltration membranes via tannic acid and irons layer-by-layer self-assembly for dye separation. Appl. Surf. Sci. 2020, 515, 146063. [Google Scholar] [CrossRef]
- Liu, S.; Fang, X.F.; Lou, M.M.; Qi, Y.H.; Li, R.; Chen, G.; Li, Y.L.; Liu, Y.B.; Li, F. Construction of Loose Positively Charged NF Membrane by Layer-by-Layer Grafting of Polyphenol and Polyethyleneimine on the PES/Fe Substrate for Dye/Salt Separation. Membranes 2021, 11, 699. [Google Scholar] [CrossRef]
- Fang, J.; Liu, G.; Chen, C.; Lin, C.; Zhang, B.; Jin, H.; Chen, Y.; Lu, J.; Zhu, L. Intrinsically antibacterial thin film composite membranes with supramolecularly assembled lysozyme nanofilm as selective layer for molecular separation. Sep. Purif. Technol. 2021, 254, 117585. [Google Scholar] [CrossRef]
- Gu, J.; Su, Y.; Liu, P.; Li, P.; Yang, P. An Environmentally Benign Antimicrobial Coating Based on a Protein Supramolecular Assembly. ACS Appl. Mater. Interfaces 2017, 9, 198–210. [Google Scholar] [CrossRef]
- Rahim, M.A.; Ejima, H.; Cho, K.L.; Kempe, K.; Müllner, M.; Best, J.P.; Caruso, F. Coordination-Driven Multistep Assembly of Metal-Polyphenol Films and Capsules. Chem. Mater. 2014, 26, 1645–1653. [Google Scholar] [CrossRef]
- Otitoju, T.A.; Ahmad, A.L.; Ooi, B.S. Recent advances in hydrophilic modification and performance of polyethersulfone (PES) membrane via additive blending. RSC Adv. 2018, 8, 22710–22728. [Google Scholar] [CrossRef] [PubMed]
- Malczewska, B.; Zak, A. Structural Changes and Operational Deterioration of the Uf Polyethersulfone (Pes) Membrane Due to Chemical Cleaning. Sci. Rep. 2019, 9, 422. [Google Scholar] [CrossRef] [PubMed]
- Meng, Y.; Shu, L.; Xie, L.-H.; Zhao, M.; Liu, T.; Li, J.-R. High performance nanofiltration in BUT-8(A)/PDDA mixed matrix membrane fabricated by spin-assisted layer-by-layer assembly. J. Taiwan Inst. Chem. Eng. 2020, 115, 331–338. [Google Scholar] [CrossRef]
- Xiong, S.; Han, C.; Phommachanh, A.; Li, W.; Xu, S.; Wang, Y. High-performance loose nanofiltration membrane prepared with assembly of covalently cross-linked polyethyleneimine-based polyelectrolytes for textile wastewater treatment. Sep. Purif. Technol. 2021, 274, 119105. [Google Scholar] [CrossRef]
- Ding, W.; Zhuo, H.; Bao, M.; Li, Y.; Lu, J. Fabrication of organic-inorganic nanofiltration membrane using ordered stacking SiO2 thin film as rejection layer assisted with layer-by-layer method. Chem. Eng. J. 2017, 330, 337–344. [Google Scholar] [CrossRef]
- Wei, X.; Wang, S.; Shi, Y.; Xiang, H.; Chen, J. Application of positively charged composite hollow-fiber nanofiltration membranes for dye purification. Ind. Eng. Chem. Res. 2014, 53, 14036–14045. [Google Scholar] [CrossRef]
- Chen, P.; Ma, X.; Zhong, Z.; Zhang, F.; Xing, W.; Fan, Y. Performance of ceramic nanofiltration membrane for desalination of dye solutions containing NaCl and Na2SO4. Desalination 2017, 404, 102–111. [Google Scholar] [CrossRef]
- Emadzadeh, D.; Lau, W.J.; Rahbari-Sisakht, M.; Daneshfar, A.; Ghanbari, M.; Mayahi, A.; Matsuura, T.; Ismail, A.F. A novel thin film nanocomposite reverse osmosis membrane with superior anti-organic fouling affinity for water desalination. Desalination 2015, 368, 106–113. [Google Scholar] [CrossRef]
- Liu, S.; Wang, Z.; Ban, M.; Song, P.; Song, X.; Khan, B. Chelation-assisted in situ self-assembly route to prepare the loose PAN-based nanocomposite membrane for dye desalination. J. Membr. Sci. 2018, 566, 168–180. [Google Scholar] [CrossRef]
- Zinadini, S.; Zinatizadeh, A.A.; Rahimi, M.; Vatanpour, V.; Zangeneh, H. Preparation of a novel antifouling mixed matrix PES membrane by embedding graphene oxide nanoplates. J. Membr. Sci. 2014, 453, 292–301. [Google Scholar] [CrossRef]
- Zhang, J.; Qin, Z.; Yang, L.; Guo, H.; Han, S. Activation promoted ionic liquid modification of reverse osmosis membrane towards enhanced permeability for desalination. J. Taiwan Inst. Chem. Eng. 2017, 80, 25–33. [Google Scholar] [CrossRef]
- Shan, L.; Fan, H.; Guo, H.; Ji, S.; Zhang, G. Natural organic matter fouling behaviors on superwetting nanofiltration membranes. Water Res. 2016, 93, 121–132. [Google Scholar] [CrossRef] [PubMed]
- Alventosa-deLara, E.; Barredo-Damas, S.; Zuriaga-Agustí, E.; Alcaina-Miranda, M.I.; Iborra-Clar, M.I. Ultrafiltration ceramic membrane performance during the treatment of model solutions containing dye and salt. Sep. Purif. Technol. 2014, 129, 96–105. [Google Scholar] [CrossRef]
- Alves, M.J.; Ferreira, I.C.; Froufe, H.J.; Abreu, R.M.; Martins, A.; Pintado, M. Antimicrobial activity of phenolic compounds identified in wild mushrooms, SAR analysis and docking studies. J. Appl. Microbiol. 2013, 115, 346–357. [Google Scholar] [CrossRef] [PubMed]
- Weng, X.-D.; Ji, Y.-L.; Ma, R.; Zhao, F.-Y.; An, Q.-F.; Gao, C.-J. Superhydrophilic and antibacterial zwitterionic polyamide nanofiltration membranes for antibiotics separation. J. Membr. Sci. 2016, 510, 122–130. [Google Scholar] [CrossRef]
- Li, X.; Cao, Y.; Yu, H.; Kang, G.; Jie, X.; Liu, Z.; Yuan, Q. A novel composite nanofiltration membrane prepared with PHGH and TMC by interfacial polymerization. J. Membr. Sci. 2014, 466, 82–91. [Google Scholar] [CrossRef]
- Liu, M.; Zhou, C.; Dong, B.; Wu, Z.; Wang, L.; Yu, S.; Gao, C. Enhancing the permselectivity of thin-film composite poly(vinyl alcohol) (PVA) nanofiltration membrane by incorporating poly(sodium-p-styrene-sulfonate) (PSSNa). J. Membr. Sci. 2014, 463, 173–182. [Google Scholar] [CrossRef]
- Bai, L.; Liu, Y.; Ding, A.; Ren, N.; Li, G.; Liang, H. Fabrication and characterization of thin-film composite (TFC) nanofiltration membranes incorporated with cellulose nanocrystals (CNCs) for enhanced desalination performance and dye removal. Chem. Eng. J. 2019, 358, 1519–1528. [Google Scholar] [CrossRef]
- Zhang, L.; Xu, L.; Yu, H.; Yao, P.; Zhang, M.; Guo, F.; Yu, L. Capsaicin mimic-polyethyleneimine crosslinked antifouling loose nanofiltration membrane for effective dye/salt wastewater treatment. J. Membr. Sci. 2022, 641, 119923. [Google Scholar] [CrossRef]
- Liu, Y.; Wang, J.; Wang, Y.; Zhu, H.; Xu, X.; Liu, T.; Hu, Y. High-flux robust PSf-b-PEG nanofiltration membrane for the precise separation of dyes and salts. Chem. Eng. J. 2021, 405, 127051. [Google Scholar] [CrossRef]
- Du, X.; Li, Y.; Sun, K.; Liu, H.; Chen, M.; Huang, Q. Preparation of PMIA loose nanofiltration membrane with electrostatic layer-by-layer self-assembled for dye/salt filtration. Environ. Chem. Eng. 2024, 12, 112204. [Google Scholar] [CrossRef]
- Wang, X.-L.; Qin, W.; Wang, L.-X.; Zhao, K.-Y.; Wang, H.-C.; Liu, H.-Y.; Wei, J.-F. Desalination of dye utilizing carboxylated TiO2/calcium alginate hydrogel nanofiltration membrane with high salt permeation. Sep. Purif. Technol. 2020, 253, 117475. [Google Scholar] [CrossRef]
- Li, P.; Wang, Z.; Yang, L.; Zhao, S.; Song, P.; Khan, B. A novel loose-NF membrane based on the phosphorylation and cross-linking of polyethyleneimine layer on porous PAN UF membranes. J. Membr. Sci. 2018, 555, 56–68. [Google Scholar] [CrossRef]
- Zhao, S.; Wang, Z. A loose nano-filtration membrane prepared by coating HPAN UF membrane with modified PEI for dye reuse and desalination. J. Membr. Sci. 2017, 524, 214–224. [Google Scholar] [CrossRef]
- Ding, J.; Wu, H.; Wu, P. Preparation of highly permeable loose nanofiltration membranes using sulfonated polyethylenimine for effective dye/salt fractionation. Chem. Eng. J. 2020, 396, 125199. [Google Scholar] [CrossRef]
- Zhang, P.; Gong, J.-L.; Zeng, G.-M.; Song, B.; Cao, W.; Liu, H.-Y.; Huan, S.-Y.; Peng, P. Novel “loose” GO/MoS2 composites membranes with enhanced permeability for effective salts and dyes rejection at low pressure. J. Membr. Sci. 2019, 574, 112–123. [Google Scholar] [CrossRef]
Disclaimer/Publisher’s Note: The statements, opinions and data contained in all publications are solely those of the individual author(s) and contributor(s) and not of MDPI and/or the editor(s). MDPI and/or the editor(s) disclaim responsibility for any injury to people or property resulting from any ideas, methods, instructions or products referred to in the content. |
© 2025 by the authors. Licensee MDPI, Basel, Switzerland. This article is an open access article distributed under the terms and conditions of the Creative Commons Attribution (CC BY) license (https://creativecommons.org/licenses/by/4.0/).